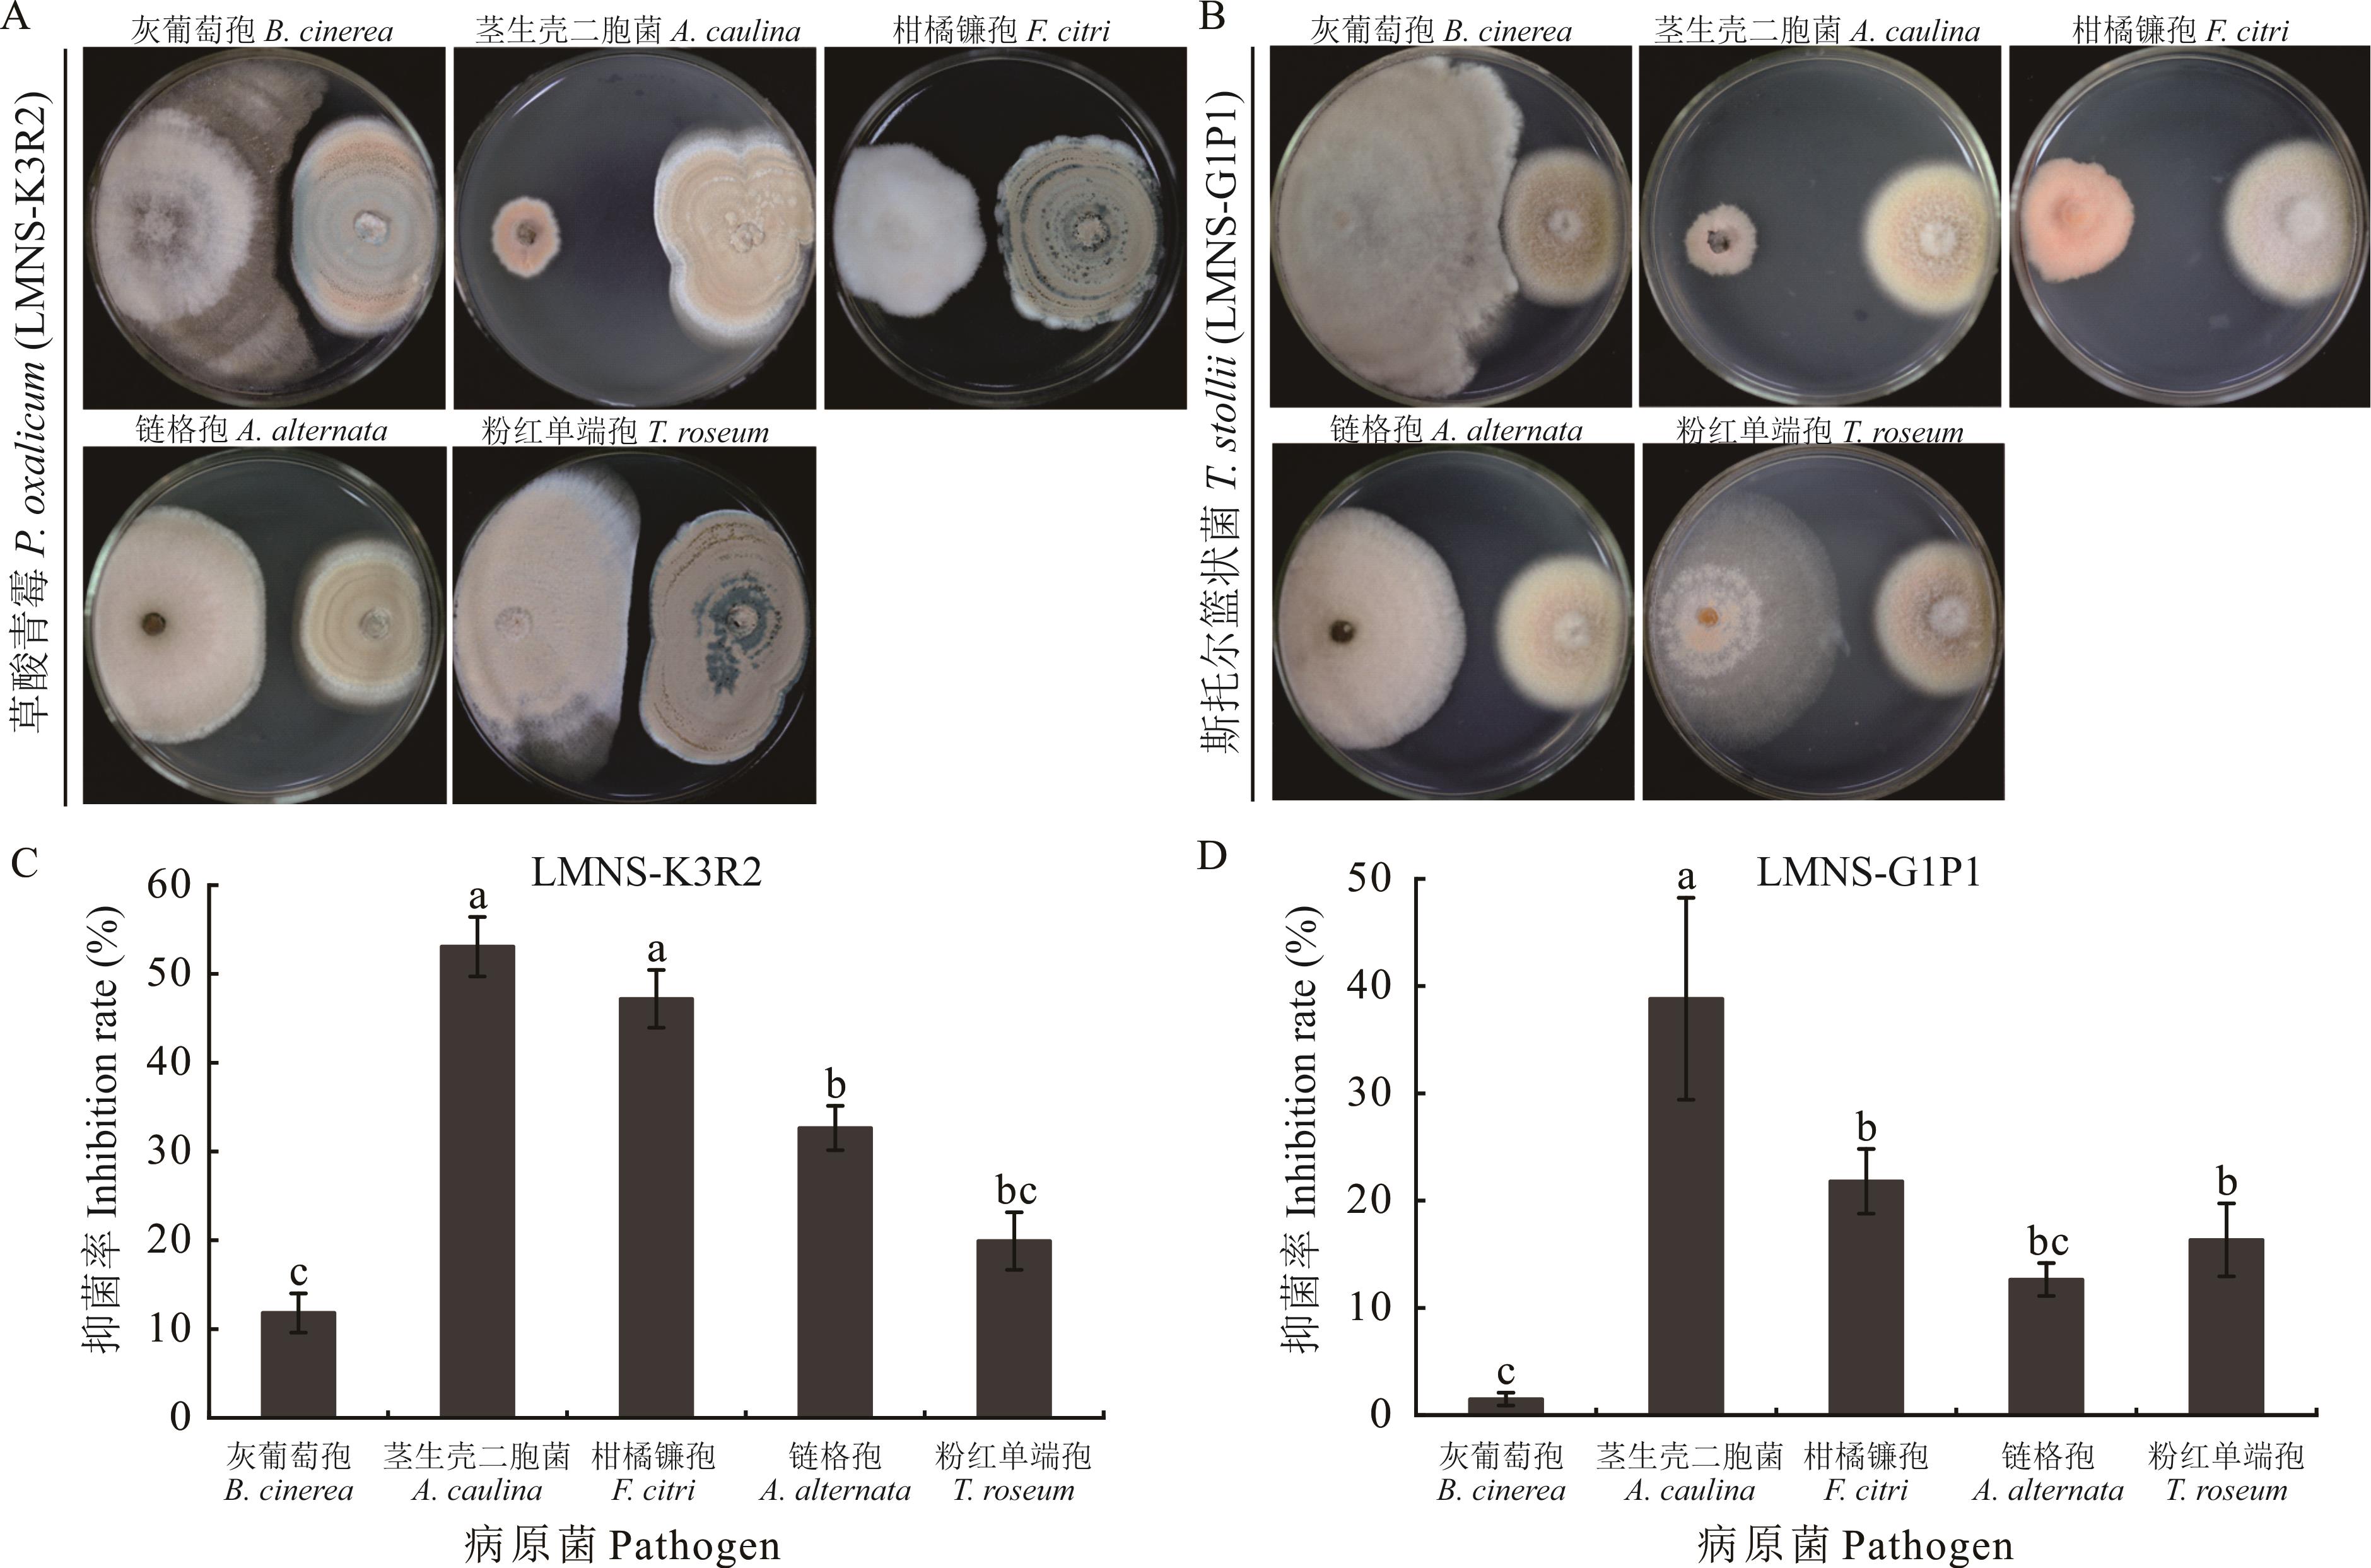

ISSN 1004-5759 CN 62-1105/S


草业学报 ›› 2025, Vol. 34 ›› Issue (11): 98-113.DOI: 10.11686/cyxb2025052
秦楠1,2( ), 曹瑞鹏1, 高婧涵1, 彭玉飞1, 田淼1, 吕红1,2, 任璐1,2, 殷辉1,2(
), 曹瑞鹏1, 高婧涵1, 彭玉飞1, 田淼1, 吕红1,2, 任璐1,2, 殷辉1,2( ), 赵晓军1,2(
), 赵晓军1,2( )
)
收稿日期:2025-02-25
修回日期:2025-04-15
出版日期:2025-11-20
发布日期:2025-10-09
通讯作者:
殷辉,赵晓军
作者简介:yinhui0806@163.com基金资助:
Nan QIN1,2( ), Rui-peng CAO1, Jing-han GAO1, Yu-fei PENG1, Miao TIAN1, Hong LYU1,2, Lu REN1,2, Hui YIN1,2(
), Rui-peng CAO1, Jing-han GAO1, Yu-fei PENG1, Miao TIAN1, Hong LYU1,2, Lu REN1,2, Hui YIN1,2( ), Xiao-jun ZHAO1,2(
), Xiao-jun ZHAO1,2( )
)
Received:2025-02-25
Revised:2025-04-15
Online:2025-11-20
Published:2025-10-09
Contact:
Hui YIN,Xiao-jun ZHAO
摘要:
藜麦作为一种新引入我国的作物,因其超高的营养价值而备受瞩目。为明确藜麦种子内生真菌的种群结构和功能特性,对4个品种藜麦种子可培养内生真菌进行分离培养,综合形态学和系统发育分析对其进行了鉴定,并对其致病性和抑菌作用进行了探究。结果表明,4种藜麦种子中分离到6属9种可培养内生真菌,包含链格孢、黄曲霉、聚多曲霉、布氏镰孢、棒状镰孢、甜菜新凸轮孢、藜新凸轮孢、草酸青霉和斯托尔篮状菌。链格孢是4个品种都包含的内生菌,分离频率最高,为64.42%,其次为黄曲霉和草酸青霉,分离频率依次为11.66%、9.20%。9种可培养内生真菌中,5种可侵染藜麦叶片,为布氏镰孢、棒状镰孢、链格孢、藜新凸轮孢和甜菜新凸轮孢;2种对藜麦病原(灰葡萄孢、茎生壳二胞菌、柑橘镰孢、链格孢、粉红单端孢)有抑制作用,为草酸青霉和斯托尔篮状菌。藜麦种子可培养内生真菌种群结构丰富,在植物病害生物防治方面具有重要的应用潜力。
秦楠, 曹瑞鹏, 高婧涵, 彭玉飞, 田淼, 吕红, 任璐, 殷辉, 赵晓军. 藜麦种子可培养内生真菌鉴定及分析[J]. 草业学报, 2025, 34(11): 98-113.
Nan QIN, Rui-peng CAO, Jing-han GAO, Yu-fei PENG, Miao TIAN, Hong LYU, Lu REN, Hui YIN, Xiao-jun ZHAO. Identification and analysis of culturable endophytic fungi from quinoa seeds[J]. Acta Prataculturae Sinica, 2025, 34(11): 98-113.
| 基因Gene | 引物Primers | 序列Sequences (5′→3′) | 参考文献References |
|---|---|---|---|
| ITS | ITS1 | TCCGTAGGTGAACCTGCGG | [ |
| ITS4 | TCCTCCGCTTATTGATATGC | ||
| tef1 | EF1-728F | CATCGAGAAGTTCGAGAAGG | [ |
| TEF1LLErev | AACTTGCAGGCAATGTGG | ||
| EF-1 | ATGGGTAAGGARGACAAGAC | [ | |
| EF-2 | GGARGTACCAGTSATCATGTT | ||
| rpb2 | Frpb2-F | CCTGCTGGCCAAGCTGT | 生工合成Synthesized by Sangon Biotech |
| Frpb2-R | CAGATACCTAAGATCATAC | ||
| CaM | CMD5 | CCGAGTACAAGGARGCCTTC | [ |
| CMD6 | CCGATRGAGGTCATRACGTGG | ||
| Alt a 1 | Alt a 1-F | GCTGCACCTCTCGAGTCTC | [ |
| Alt a 1-R | AAGTCCTTAGGGCCGTTACC | ||
| endoPG | endoPG-F | GGCACAACTTTGGACCTCTC | [ |
| endoPG-R | TGATGACGTTGTTGCTGGAG | ||
| OPA10-2 | OPA10-2-F | TTAGTGCAGCTCTCTCAAACG | [ |
| OPA10-2-R | TTGAACTTCGTAACCAGGGC |
表1 本研究中涉及的引物
Table 1 Primers used in this study
| 基因Gene | 引物Primers | 序列Sequences (5′→3′) | 参考文献References |
|---|---|---|---|
| ITS | ITS1 | TCCGTAGGTGAACCTGCGG | [ |
| ITS4 | TCCTCCGCTTATTGATATGC | ||
| tef1 | EF1-728F | CATCGAGAAGTTCGAGAAGG | [ |
| TEF1LLErev | AACTTGCAGGCAATGTGG | ||
| EF-1 | ATGGGTAAGGARGACAAGAC | [ | |
| EF-2 | GGARGTACCAGTSATCATGTT | ||
| rpb2 | Frpb2-F | CCTGCTGGCCAAGCTGT | 生工合成Synthesized by Sangon Biotech |
| Frpb2-R | CAGATACCTAAGATCATAC | ||
| CaM | CMD5 | CCGAGTACAAGGARGCCTTC | [ |
| CMD6 | CCGATRGAGGTCATRACGTGG | ||
| Alt a 1 | Alt a 1-F | GCTGCACCTCTCGAGTCTC | [ |
| Alt a 1-R | AAGTCCTTAGGGCCGTTACC | ||
| endoPG | endoPG-F | GGCACAACTTTGGACCTCTC | [ |
| endoPG-R | TGATGACGTTGTTGCTGGAG | ||
| OPA10-2 | OPA10-2-F | TTAGTGCAGCTCTCTCAAACG | [ |
| OPA10-2-R | TTGAACTTCGTAACCAGGGC |
| 品种Variety | 属名Genus | 种名Species | 分离频率Separation frequencies (%) | 数目Numbers |
|---|---|---|---|---|
| 1、2、3、4 | 链格孢属Alternaria | 链格孢A. alternata | 64.42 | 105 |
| 3、4 | 曲霉属Aspergillus | 黄曲霉A. flavus | 11.66 | 19 |
| 2 | 聚多曲霉A. sydowii | 0.61 | 1 | |
| 2 | 镰孢属Fusarium | 布氏镰孢F. boothii | 0.61 | 1 |
| 3 | 棒状镰孢F. clavum | 1.23 | 2 | |
| 3 | 新凸轮孢属Neocamarosporium | 藜新凸轮孢N. chenopodii | 0.61 | 1 |
| 1 | 甜菜新凸轮孢N. betae | 0.61 | 1 | |
| 1、3 | 青霉属Penicillium | 草酸青霉P. oxalicum | 9.20 | 15 |
| 1 | 篮状菌属Talaromyces | 斯托尔篮状菌T. stollii | 0.61 | 1 |
| 1、2、3、4 | 未知Unknown | 未知Unknown | 10.43 | 17 |
表2 藜麦种子可培养内生真菌分离结果
Table 2 Results of endophytic fungi isolation from quinoa seeds
| 品种Variety | 属名Genus | 种名Species | 分离频率Separation frequencies (%) | 数目Numbers |
|---|---|---|---|---|
| 1、2、3、4 | 链格孢属Alternaria | 链格孢A. alternata | 64.42 | 105 |
| 3、4 | 曲霉属Aspergillus | 黄曲霉A. flavus | 11.66 | 19 |
| 2 | 聚多曲霉A. sydowii | 0.61 | 1 | |
| 2 | 镰孢属Fusarium | 布氏镰孢F. boothii | 0.61 | 1 |
| 3 | 棒状镰孢F. clavum | 1.23 | 2 | |
| 3 | 新凸轮孢属Neocamarosporium | 藜新凸轮孢N. chenopodii | 0.61 | 1 |
| 1 | 甜菜新凸轮孢N. betae | 0.61 | 1 | |
| 1、3 | 青霉属Penicillium | 草酸青霉P. oxalicum | 9.20 | 15 |
| 1 | 篮状菌属Talaromyces | 斯托尔篮状菌T. stollii | 0.61 | 1 |
| 1、2、3、4 | 未知Unknown | 未知Unknown | 10.43 | 17 |

图1 菌株LMNS-G1P1的菌落形态(A、B)、分生孢子梗(C)和分生孢子(D)CYA: 察氏酵母膏琼脂培养基Czapek yeast autolysate agar; MEA: 麦芽浸粉琼脂培养基Malt extract agar medium. 下同The same below.
Fig.1 Colonies morphology (A, B), conidiophores (C), and conidia (D) of strain LMNS-G1P1

图2 基于多基因构建的系统发育树A: 菌株LMNS-G1P1和LMNS-K3R2基于CaM和ITS序列构建的系统发育树Phylogenetic tree constructed for strains LMNS-G1P1 and LMNS-K3R2 based on CaM and ITS sequences; B: 菌株LMNS-G2M1、LMNS-G4M4和LMNS-C1M1基于Alt a 1、endoPG和OPA10-2序列构建的系统发育树Phylogenetic tree constructed for strains LMNS-G2M1, LMNS-G4M4, and LMNS-C1M1 based on Alt a 1, endoPG, and OPA10-2 sequences.
Fig.2 Phylogenetic tree constructed based on multiple genes

图3 菌株LMNS-K3R2的菌落形态(A、B)、分生孢子梗(C)和分生孢子(D)PDA: 马铃薯葡萄糖琼脂培养基Potato dextrose agar. 下同The same below.
Fig.3 Colonies morphology (A, B), conidiophores (C), and conidia (D) of strain LMNS-K3R2

图5 基于单基因构建的系统发育树A: 菌株LMNS-K3D1和LMNS-K2R1基于CaM序列构建的系统发育树Phylogenetic tree constructed for strains LMNS-K3D1 and LMNS-K2R1 based on the CaM sequence; B: 菌株LMNS-G2P3和LMNS-K3P1基于tef1序列构建的系统发育树Phylogenetic tree constructed for strains LMNS-G2P3 and LMNS-K3P1 based on the tef1 sequence; C: 菌株LMNS-C3M2和LMNS-C1R3基于ITS序列构建的系统发育树Phylogenetic tree constructed for strains LMNS-C3M2 and LMNS-C1R3 based on the ITS sequence.
Fig.5 Phylogenetic tree constructed based on a single gene

图6 菌株LMNS-K2R1的菌落形态(A、B)、分生孢子梗(C)和分生孢子(D)RBM: 孟加拉红培养基Rose bengal medium.
Fig.6 Colonies morphology (A, B), conidiophores (C), and conidia (D) of strain LMNS-K2R1

图13 藜麦叶片接种6种内生真菌后的症状A: 对照组未接种病原; B: 接种N. betae 1 d; C: 接种A. flavus 3 d; D: 接种F. clavum 2 d; E: 接种N. chenopodii 2 d; F: 接种F. boothii 3 d; G: 接种A. alternata 3 d。A: The control group was not inoculated with pathogens; B: Symptoms of quinoa leaves inoculated with N. betae for 1 d; C: Symptoms of quinoa leaves inoculated with A. flavus for 3 d; D: Symptoms of quinoa leaves inoculated with F. clavum for 2 d; E: Symptoms of quinoa leaves inoculated with N. chenopodii for 2 d; F: Symptoms of quinoa leaves inoculated with F. boothii for 3 d; G: Symptoms of quinoa leaves inoculated with A. alternata for 3 d.
Fig.13 Symptoms of quinoa leaf inoculated with mycelia of endophytic fungi
图14 藜麦种子内生真菌对5种病原菌的抑制作用不同小写字母表示在P<0.05水平差异显著。Different lowercase letters indicate significant difference in P<0.05 level.
Fig.14 Inhibitory effect of endophytic fungi from quinoa seeds against five pathogen
| [1] | Gongbu T, Wang M, Zhang C X, et al. Preliminary study of biological characters of quinoa in Tibet. Acta Agriculturae Boreali-Occidentalis Sinica, 1994(4): 81-86. |
| 贡布扎西, 旺姆, 张崇玺, 等. 南美藜在西藏的生物学特性研究. 西北农业学报, 1994(4): 81-86. | |
| [2] | Zurita-silva A, Funtes F, Zamora P, et al. Breeding quinoa (Chenopodium quinoa willd.) potential and perspectives. Molecular Breeding, 2014, 34: 13-30. |
| [3] | Liu X H, Cui Y J, Wang J K, et al. Nutritional and functional properties of quinoa and its application in plant-based foods. Journal of the Chinese Cereals and Oils Association, 2025, (2025-03-26)[2025-04-15]. https://link.cnki.net/urlid/11.2864.TS.20250326.1559.006. |
| 刘兴浩, 崔亚君, 王佳凯, 等. 藜麦营养功能特性及其在植物基食品中的应用. 中国粮油学报, 2025 (2025-03-26)[2025-04-15]. https://link.cnki.net/urlid/11.2864.TS.20250326.1559.006. | |
| [4] | Yang Z T, Xu R D, Chang Y Y, et al. Quality characteristics and flavor components of quinoa rice during storage at room temperature. Science and Technology of Food Industry, 2025, (2025-03-19)[2025-04-15]. https://link.cnki.net/urlid/11.1759.TS.20250319.1009.007. |
| 杨梓婷, 徐润东, 畅莹莹, 等. 藜麦饭常温贮藏过程中品质特性与风味成分的变化. 食品工业科技, 2025, (2025-03-19)[2025-04-15]. https://link.cnki.net/urlid/11.1759.TS.20250319.1009.007. | |
| [5] | Wang C J, Zhao X W, Lu G Q, et al. A review of characteristics and utilization of Chenopodium quinoa. Journal of Zhejiang A & F University, 2014, 31(2): 296-301. |
| 王晨静, 赵习武, 陆国权, 等. 藜麦特性及开发利用研究进展. 浙江农林大学学报, 2014, 31(2): 296-301. | |
| [6] | Wang Y, Pan X W, Du H S, et al. Research progress in the utilization and stress resistance on the plant resource of quinoa. Journal of Jilin Normal University (Natural Science Edition), 2023, 44(4): 118-122. |
| 王洋, 潘晓为, 杜会石, 等. 藜麦植物资源开发利用与抗逆性研究进展. 吉林师范大学学报(自然科学版), 2023, 44(4): 118-122. | |
| [7] | Ren G X, Yang X S, Yao Y. Current situation of quinoa industry in China. Crops, 2015(5): 1-5. |
| 任贵兴, 杨修仕, 么杨. 中国藜麦产业现状. 作物杂志, 2015(5): 1-5. | |
| [8] | Li Z Q, Liu Y M, Li X J, et al. Current situation and trend analysis of quinoa research at home and abroad. Journal of Hebei Agricultural Sciences, 2022, 26(4): 41-46. |
| 李振奇, 刘伊明, 李晓健, 等. 国内外藜麦研究现状与趋势分析. 河北农业科学, 2022, 26(4): 41-46. | |
| [9] | Liu Z L, Zhou S Y, Liang G D, et al. Diversity analysis of endophytic fungi from Hylocereus undatus. Mycosystema, 2020, 39(4): 723-730. |
| 刘增亮, 周双云, 梁桂东, 等. 量天尺根部内生真菌的多样性. 菌物学报, 2020, 39(4): 723-730. | |
| [10] | Jacobsen S, Liu F, Jensen R C. Does root-sourced ABA play a role for regulation of stomata under drought in quinoa (Chenopodium quinoa Willd.). Scientia Horticulturae, 2009, 122(2): 281-287. |
| [11] | Adolf V I, Jacobsen S, Shabala S. Salt tolerance mechanisms in quinoa (Chenopodium quinoa Willd.). Environmental and Experimental Botany, 2013, 92: 43-54. |
| [12] | Li J. Isolation, identification and diversity analysis of endophytic fungi from sweet potatoes. Chongqing: Southwest University, 2020. |
| 李静. 甘薯内生真菌的分离鉴定及多样性分析. 重庆: 西南大学, 2020. | |
| [13] | Tang Q Y, Zhu J, Chu M, et al. Community composition and distribution of endophytic fungi in Salicornia europaea from the northern Xinjiang. Journal of Arid Land Resources and Environment, 2021, 35(5): 137-143. |
| 唐琦勇, 朱静, 楚敏, 等. 北疆盐角草内生真菌群落组成和分布. 干旱区资源与环境, 2021, 35(5): 137-143. | |
| [14] | Wang S M. Preliminary studies on the isolation and identification of endophytic fungi and their secondary metabolites in Tulipa sp. Yili: Yili Normal University, 2023. |
| 王世苗. 郁金香属植物内生真菌分离、鉴定及其次生代谢产物的初步研究. 伊犁: 伊犁师范大学, 2023. | |
| [15] | Song J J, Lu L L, Li J J, et al. Diversity, antifungal and antibacterial activity of endophytic fungi from Thespesia populnea. Southwest China Journal of Agricultural Sciences, 2024, 37(2): 326-336. |
| 宋静静, 陆柳琳, 黎俊杰, 等. 杨叶肖槿内生真菌多样性和抑菌活性研究. 西南农业学报, 2024, 37(2): 326-336. | |
| [16] | Wang H X, Yu Y R, Huang B K. Diversity of culturable endophytic fungi from Broussonetia papyrifera. Mycosystema, 2020, 39(12): 2399-2408. |
| 王红霞, 余亚茹, 黄宝康. 构树可培养内生真菌的多样性初探. 菌物学报, 2020, 39(12): 2399-2408. | |
| [17] | Zhang L G, Wei X Y, Ma C X. Endophytic fungi living in medicinal plants as new sources of bioactive substances. Pharmaceutical Biotechnology, 2011, 18(5): 453-456. |
| 张黎光, 魏希颖, 马彩霞. 药用植物内生真菌生物活性物质的新来源. 药物生物技术, 2011, 18(5): 453-456. | |
| [18] | Liu Y, Meng X H, Lyu H, et al. Isolation of endophytic fungi from the leaves of Cichorium intybus and analysis of their antifungal activity against phytopathogens. Journal of Plant Resources and Environment, 2025, 34(1): 118-121. |
| 刘洋, 孟秀花, 吕寒, 等. 菊苣叶内生真菌的分离及其抗植物病原菌活性分析. 植物资源与环境学报, 2025, 34(1): 118-121. | |
| [19] | González-Teuber M, Vilo C, Bascuñán-Godoy L. Molecular characterization of endophytic fungi associated with the roots of Chenopodium quinoa inhabiting the Atacama Desert, Chile. Genomics Data, 2017, 11: 109-112. |
| [20] | Hu R, Qiao J H Z, Hao Y F, et al. Community structure and diversity analysis of culturable endophytic bacteria in diseased quinoa. Acta Agriculturae Universitatis Jiangxiensis, 2022, 44(6): 1373-1386. |
| 呼荣, 乔佳慧子, 郝玉凡, 等. 患病青白藜可培养内生菌的群落结构及多样性分析. 江西农业大学学报, 2022, 44(6): 1373-1386. | |
| [21] | Xie T, Shen S, Hu R, et al. Screening, identification, and growth promotion of antagonistic endophytes associated with Chenopodium quinoa against quinoa pathogens. Phytopathology, 2023, 113(10): 1839-1852. |
| [22] | Zhu X F, Zhuomaqucuo, Sun Y, et al. Preliminary study on the bacterial strain in quinoa seeds. Journal of Plateau Agriculture, 2020, 4(5): 470-480, 544. |
| 朱雪峰, 卓玛曲措, 孙玉, 等. 藜麦种子内生生防菌株初探. 高原农业, 2020, 4(5): 470-480, 544. | |
| [23] | Wang S P, Yang G L, Chen J, et al. Culturable endophytic fungal diversity of quinoa seeds in Tibet, southwest China. Mycosystema, 2022, 41(2): 204-213. |
| 王生萍, 杨郭林, 陈娟, 等. 西藏昆诺阿藜种子可培养内生真菌多样性. 菌物学报, 2022, 41(2): 204-213. | |
| [24] | Nirenberg H. Untersuchungen über die morphologische und biologische differenzierung in der Fusarium-sektion liseola. Berlin: Kommissionsverlag Paul Parey, 1976: 1-117. |
| [25] | Gardes M, Bruns T D. ITS primers with enhanced specificity for basidiomycetes-application to the identification of mycorrhizae and rusts. Molecular Ecology, 1993, 2(2): 113-118. |
| [26] | Carbone I, Kohn L M. A method for designing primer sets for speciation studies in filamentous ascomycetes. Mycologia, 1999, 91(3): 553-556. |
| [27] | Jaklitsch W M, Komon M, Kubicek C P, et al. Hypocrea voglmayrii sp. nov. from the Austrian Alps represents a new phylogenetic clade in Hypocrea/Trichoderma. Mycologia, 2005, 97(6): 1365-1378. |
| [28] | Hong S B, Go S J, Shin H D, et al. Polyphasic taxonomy of Aspergillus fumigatus and related species. Mycologia, 2005, 97: 1316-1329. |
| [29] | Woudenberg J H C, Truter M, Groenewald J Z, et al. Large-spored Alternaria pathogens in section Porri disentangled. Studies in Mycology, 2014, 79: 1-47. |
| [30] | Andrew M, Peever T L, Pryor B M. An expanded multilocus phylogeny does not resolve morphological species within the small-spored Alternaria species complex. Mycologia, 2009, 101(1): 95-109. |
| [31] | Lei Z J, Wu Y M, Liu Z H, et al. Endophytes of Ziziphus jujube: Isolation, identification and antibacterial activity in saline-alkali field. Chinese Agricultural Science Bulletin, 2023, 39(27): 140-148. |
| 雷早娟, 武亚明, 刘子欢, 等. 盐碱地冬枣内生真菌的分离鉴定及抑菌活性研究. 中国农学通报, 2023, 39(27): 140-148. | |
| [32] | Niu X G, Song L C, Han M, et al. Diversity of endophytic fungi of Suaeda heteroptera Kitag. Microbiology China, 2012, 39(10): 1388-1395. |
| 钮旭光, 宋立超, 韩梅, 等. 盐生植物翅碱蓬的内生真菌多样性分析. 微生物学通报, 2012, 39(10): 1388-1395. | |
| [33] | Shao M Q, Li S, Sun Y, et al. Characteristics of culturable endophytic fungal communities detected at different growing stages of Tamarix ramosissima. Journal of Fungal Research, 2024, 22(3): 290-300. |
| 邵明琦, 李姝, 孙月, 等. 柽柳不同生育期可培养内生真菌群落特征. 菌物研究, 2024, 22(3): 290-300. | |
| [34] | Li H L, Ma B, Zhang X L, et al. Diversity of culturable endophytic fungi of common reed Phragmites australis in coastal wetland. Chinese Journal of Applied Ecology, 2016, 27(7): 2066-2074. |
| 李海林, 马斌, 张晓黎, 等. 滨海湿地植物芦苇可培养内生真菌的多样性. 应用生态学报, 2016, 27(7): 2066-2074. | |
| [35] | Chen Y L, Tian M, Sun J W, et al. Biological characteristics of the pathogen causing Alternaria leaf spot on quinoa. Mycosystema, 2022, 41(5): 713-729. |
| 陈亚蕾, 田淼, 孙江伟, 等. 昆诺阿藜链格孢叶斑病病原及其生物学特性. 菌物学报, 2022, 41(5): 713-729. | |
| [36] | Yin H, Zhou J B, Chen Y L, et al. Morphology, phylogeny, and pathogenicity of Trichothecium, Alternaria, and Fusarium species associated with panicle rot on Chenopodium quinoa in Shanxi Province, China. Plant Pathology, 2022, 71(2): 344-360. |
| [37] | Yin H, Zhou J B, Lyu H, et al. Identification, pathogenicity, and fungicide sensitivity of Ascochyta caulina (teleomorph: Neocamarosporium calvescens) associated with black stem on quinoa in China. Plant Disease, 2020, 104(10): 2585-2597. |
| [38] | Wang W. Study on impact factors of maize ear rot by Aspergillus flavus and population structure of A. flavus in Sichuan Province. Chengdu: Sichuan Agricultural University, 2020. |
| 王伟. 四川玉米黄曲霉穗腐病发生因素及其病原群体分析. 成都: 四川农业大学, 2020. | |
| [39] | Shan L Y. Identification and diversity analysis of Fusarium spp. causing maize stem rot disease. Beijing: Chinese Academy of Agricultural Sciences, 2018. |
| 单柳颖. 引起玉米茎腐病的镰孢菌的分离鉴定与多样性分析. 北京: 中国农业科学院, 2018. | |
| [40] | Gilardi G, Matic S, Guarnaccia V, et al. First report of Fusarium clavum causing leaf spot and fruit rot on tomato in Italy. Plant Disease, 2021, 105(8): 2250. |
| [41] | Vaghefi N, Silva A, Koenick L B, et al. Genome resource for Neocamarosporium betae (syn. Pleospora betae), the cause of Phoma leaf spot and root rot on Beta vulgaris. Molecular Plant-Microbe Interactions, 2019, 32(7): 787-789. |
| [42] | Jing D, Yue X F, Bai Y Z, et al. The infectivity of Aspergillus flavus in peanut. Scientia Agricultura Sinica, 2021, 54(23): 5008-5020. |
| 荆丹, 岳晓凤, 白艺珍, 等. 花生黄曲霉侵染力. 中国农业科学, 2021, 54(23): 5008-5020. | |
| [43] | Gong A D. Isolation and antagonistic mechanism analyses of biocontrol agents against Fusarium and Aspergillus species. Wuhan: Huazhong Agricultural University, 2015. |
| 宫安东. 镰刀菌和黄曲霉菌生防菌的分离及拮抗机理研究. 武汉: 华中农业大学, 2015. | |
| [44] | Wueren·Ahebieerdi, Mayinuer·Alimujiang, Entemake·Bulatibai. Analysis of antibacterial active substances from endophytes of Snow Lotus in Tianshan Mountains. Chinese Traditional Patent Medicine, 2018, 40(6): 1430-1434. |
| 吾尔恩·阿合别尔迪, 玛依努尔·阿力木江, 恩特马克·布拉提白. 天山雪莲内生菌抗菌活性物质分析. 中成药, 2018, 40(6): 1430-1434. | |
| [45] | Sabuquillo P, Sztejnberg A, Cal A, et al. Relationship between number and type of adhesions of Penicillium oxalicum conidia to tomato roots and biological control of tomato wilt. Biological Control, 2008, 48(3): 244-251. |
| [46] | Wang F, Li J, Zhang H. The study on inhibition of penicillium, actinomycete and limewater to Fusarium oxysporum. Chinese Agricultural Science Bulletin, 2013, 29(12): 185-189. |
| 王芳, 李静, 张欢. 青霉菌、放线菌株和石灰水对尖孢镰刀菌抑制作用的研究. 中国农学通报, 2013, 29(12): 185-189. | |
| [47] | Zhang X F, Xiang L, Wang Y F, et al. Identification of Penicillium oxalicum A1 strain and antagonistic effects on four species of Fusarium pathogen of apple. Acta Horticulturae Sinica, 2016, 43(5): 841-852. |
| 张先富, 相立, 王艳芳, 等. 草酸青霉A1菌株的鉴定及对苹果4种镰孢病菌的拮抗作用. 园艺学报, 2016, 43(5): 841-852. | |
| [48] | Fang Q H, Yan G Z, Fang W, et al. Biocontrol effect of Penicillium oxalicum and Trichoderma asperellum on Ralstonia solanacearum. Journal of Zhejiang A&F University, 2022, 39(4): 852-859. |
| 方启航, 颜顾浙, 方伟, 等. 草酸青霉和棘孢木霉对青枯劳尔氏菌的生防效果. 浙江农林大学学报, 2022, 39(4): 852-859. | |
| [49] | Wei M, Lu L, Li C Q, et al. Identification of antagonistic fungus to camellia diseases and study of biological characteristics and antagonism effect. Journal of Henan Agricultural Sciences, 2016, 45(8): 74-80. |
| 魏蜜, 路露, 李春琪, 等. 1株油茶病害拮抗真菌的鉴定、生物学特性及拮抗作用研究. 河南农业科学, 2016, 45(8): 74-80. |
| [1] | 王昶, 闵庚梅, 张丽娟, 陆建英, 牛早霞, 魏玉明, 杨发荣. 藜麦霜霉病及其综合防控研究进展[J]. 草业学报, 2025, 34(9): 194-205. |
| [2] | 朱倩丽, 何翔, 张洋洋, 聂江山, 王常清, 芦光新. 甘肃省当归霜霉病病原鉴定[J]. 草业学报, 2024, 33(7): 142-150. |
| [3] | 刘保财, 胡学博, 张武君, 赵云青, 黄颖桢, 陈菁瑛. 石仙桃与细叶石仙桃叶绿体基因组解析及其系统发育[J]. 草业学报, 2024, 33(4): 171-185. |
| [4] | 黄祥, 何梦瑶, 王子煊, 楚光明, 江萍. 紫叶风箱果叶绿体基因组特征及绣线菊亚科系统发育分析[J]. 草业学报, 2024, 33(3): 161-173. |
| [5] | 彭斌, 崔晓宁, 张勃, 席驳鑫, 胡桂馨, 姚拓, 李昌宁, 牛奎举, 常逢美, 白建海. 10种杀虫剂对苜蓿斑蚜和牛角花齿蓟马的毒力测定及田间药效评价[J]. 草业学报, 2024, 33(12): 201-213. |
| [6] | 韩雨轩, 王瑞, 郝丽芬, 袁海滨, 林克剑. 外来入侵植物长刺蒺藜草在我国的地理分布格局及其影响因素[J]. 草业学报, 2024, 33(12): 34-44. |
| [7] | 常怡然, 史佳梅, 许冬梅, 康如龙, 马媛. 荒漠草原不同自然种群蒙古冰草生物量和养分权衡特征[J]. 草业学报, 2024, 33(11): 186-197. |
| [8] | 吕自立, 刘彬, 常凤, 马紫荆, 曹秋梅. 巴音布鲁克高寒草甸物种多样性与系统发育多样性沿海拔梯度分布格局及驱动因子[J]. 草业学报, 2023, 32(7): 12-22. |
| [9] | 丰吉, 刘志扩, 李海燕, 杨允菲, 郭健. 围栏封育和长期刈割对松嫩草地羊草和野古草种群营养繁殖特征的影响[J]. 草业学报, 2023, 32(5): 50-60. |
| [10] | 许浩宇, 赵颖, 阮倩, 朱晓林, 王宝强, 魏小红. 不同混合盐碱下藜麦幼苗的抗性研究[J]. 草业学报, 2023, 32(1): 122-130. |
| [11] | 侯丽媛, 贾举庆, 姜晓东, 王育川, 赵菁, 陈禺怀, 黄胜雄, 吴慎杰, 董艳辉. 藜麦WRKY基因的进化与多胁迫条件下的转录应答[J]. 草业学报, 2022, 31(9): 168-182. |
| [12] | 魏娜, 李艳鹏, 马艺桐, 刘文献. 全基因组水平紫花苜蓿TCP基因家族的鉴定及其在干旱胁迫下表达模式分析[J]. 草业学报, 2022, 31(1): 118-130. |
| [13] | 余肖飞, 郭晓农, 张妍, 刘子威, 张喜闻, 徐可新, 吴治勇. 响应面法优化藜麦秸秆饲料发酵工艺的研究[J]. 草业学报, 2021, 30(5): 155-164. |
| [14] | 赵颖, 魏小红, 李桃桃. 外源NO对混合盐碱胁迫下藜麦种子萌发和幼苗生长的影响[J]. 草业学报, 2020, 29(4): 92-101. |
| [15] | 陆丰帅, 阿的鲁骥, 程云湘, 侯扶江. 祁连山高寒草原土壤水分与植被盖度的关系[J]. 草业学报, 2020, 29(11): 23-32. |
| 阅读次数 | ||||||
|
全文 |
|
|||||
|
摘要 |
|
|||||